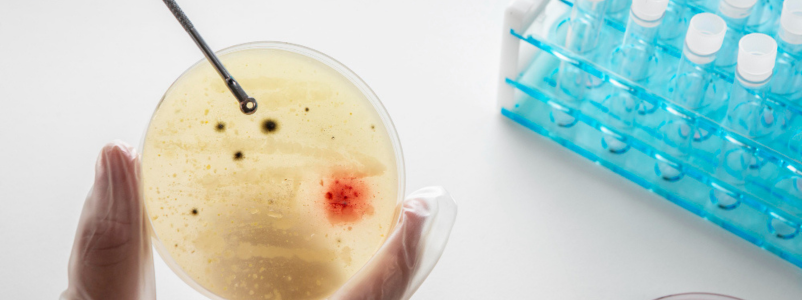
Researcher in Lab

Why Extracellular Vesicles are a Research Focus
Extracellular vesicles (EVs) are nanoparticles excreted by cells into biological fluids such as blood, urine, and cerebrospinal fluid. They include exosomes, microvesicles, and other vesicle types that carry proteins, nucleic acids, and lipids. Because they reflect the state of their parent cells, EVs are at the center of research into biomarkers, intercellular communication, and therapeutic delivery systems.
The Measurement Challenge
- EV populations are highly heterogeneous, typically ranging from about 30 nm to over 500 nm. They often coexist with proteins, lipoproteins, and other nanoparticles in complex biological matrices. Bulk methods like dynamic light scattering (DLS) or nanoparticle surface charge measurements provide average values but fail to reveal the detailed
distribution within these mixed samples. - For studies aiming to distinguish EV subtypes, detect aggregates, or correlate particle numbers with functional activity, these averaged results are not enough. A method that can resolve individual particles is essential.
How NTA Brings Clarity to EV Analysis
Nanoparticle Tracking Analysis (NTA) offers a direct view of individual particles in suspension, tracking their Brownian motion to determine size and concentration in real time. This approach is well-suited to the complexities of EVs because it provides both high-resolution size distribution data and absolute particle counts without assumptions about particle uniformity.
With NTA, researchers can:
- Quantify EV concentration accurately across different isolation methods or sample types.
- Assess size distributions to confirm enrichment of specific vesicle populations or detect contaminants.
- Monitor storage and processing effects to ensure vesicle integrity over time.
- Perform fluorescence-based analysis (when supported) to study specific EV subpopulations labeled with molecular markers.
Key Applications in EV Research
- Biomarker Discovery– EVs carry molecular signatures from their cells of origin. NTA helps researchers ink specific vesicle size profiles or concentrations with disease states, aiding in early detection strategies.
- Therapeutic Development– Engineered EVs used as delivery vehicles must be well characterized. NTA ensures that batches meet size and concentration specifications, reducing variability and improving safety profiles.
- Isolation Method Optimization– Different purification techniques, like ultracentrifugation, size-exclusion chromatography, precipitation, yield different EV populations. NTA provides immediate feedback on the efficiency and purity of these methods.
- Quality Control in Biomanufacturing– As EV-based therapeutics move toward clinical applications, NTA becomes a key part of verifying product consistency and meeting regulatory expectations.
Why This Matters
- This field of extracellular vesicle research is expanding rapidly, and robust characterization methods are critical to moving from exploratory science to reliable clinical applications. NTA delivers the level of detail needed to understand complex vesicle populations, making it a cornerstone technique in this space.
- The Envision integrates these NTA capabilities into an intuitive platform, giving researchers and developers the data they need, without unnecessary complexity, whether they’re in an academic lab or a production environment.
Advancing Extracellular Vesicles Research with NTA
As extracellular vesicles research continues to accelerate across diagnostics, therapeutics, and biomanufacturing, the demand for precise, particle-level characterization is becoming very crucial. Understanding NTA extracellular vesicles data enables researchers to move beyond averaged measurements and gain meaningful insight into vesicle heterogeneity, concentration, and size-dependent behavior. By resolving individual EVs in real time, Nanoparticle Tracking Analysis supports more confident decision-making, improved reproducibility, and stronger correlations between vesicle properties and biological function.
For laboratories focused on advancing extracellular vesicle research from discovery through translation, integrating NTA into routine workflows ensures that EV characterization is both scientifically rigorous and scalable. This level of analytical clarity is essential for developing reliable biomarkers, optimizing isolation protocols, and meeting emerging quality expectations as EV-based technologies mature.
FAQs
What makes NTA suitable for extracellular vesicles research?
NTA is uniquely suited for extracellular vesicles research because it analyzes particles individually rather than in bulk. This allows researchers to measure EV size distributions accurately and concentrations in heterogeneous samples, where multiple nanoparticle populations often coexist.
How does NTA help characterize extracellular vesicles?
NTA extracellular vesicles analysis tracks the Brownian motion of each vesicle in suspension, enabling direct determination of particle size and absolute concentration. This is especially valuable for distinguishing EV subpopulations and identifying aggregates or contaminants.
Can NTA measure different types of extracellular vesicles?
Yes. NTA can measure a broad size range of extracellular vesicles, including exosomes and microvesicles, making it suitable for comprehensive EV characterization across different isolation methods and biological samples.
Why is particle-level analysis important in EV research?
Extracellular vesicle samples are inherently heterogeneous. Particle-level analysis provided by NTA allows researchers to understand population variability, which is critical for correlating vesicle properties with biological activity, disease relevance, or therapeutic performance.
Is NTA used in both research and applied EV workflows?
Absolutely. NTA extracellular vesicles analysis is widely used in academic research, translational studies, and industrial settings, supporting everything from basic extracellular vesicle research to quality control in EV-based therapeutic development.
